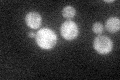
YOR035C
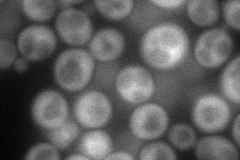
YOR035C
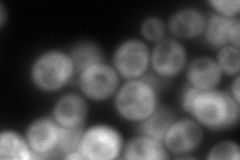
YOR035C

View description
Protein containing a UCS (UNC-45/CRO1/SHE4) domain, binds to myosin motor domains to regulate myosin function; involved in endocytosis, polarization of the actin cytoskeleton, and asymmetric mRNA localization
Localization:
Intensity:
Fold change:
Significance:
-
C’ GFP library in SD
cytosol29.9 -
N' NOP1pr-GFP in SD
cytosol71.2467 -
N' TEF2pr-mCherry in SD
cytosol28.8668 -
N' NATIVEpr-GFP in SD

cytosol30.2569 -
N' TEF2pr-VC and Cyto-VN in SD

cytosol47.8793 -
C’ GFP library in SD+DTT

cytosol38.611.29No -
C’ GFP library in SD+H2O2

cytosol30.611.02No -
C’ GFP library in Starvation Media

cytosol51.061.7Yes -
C’ GFP library on the background of Pup2-DaMP

cytosol -
C’ GFP library on the background of CCT mutant

cytosol29.41680.983735No
